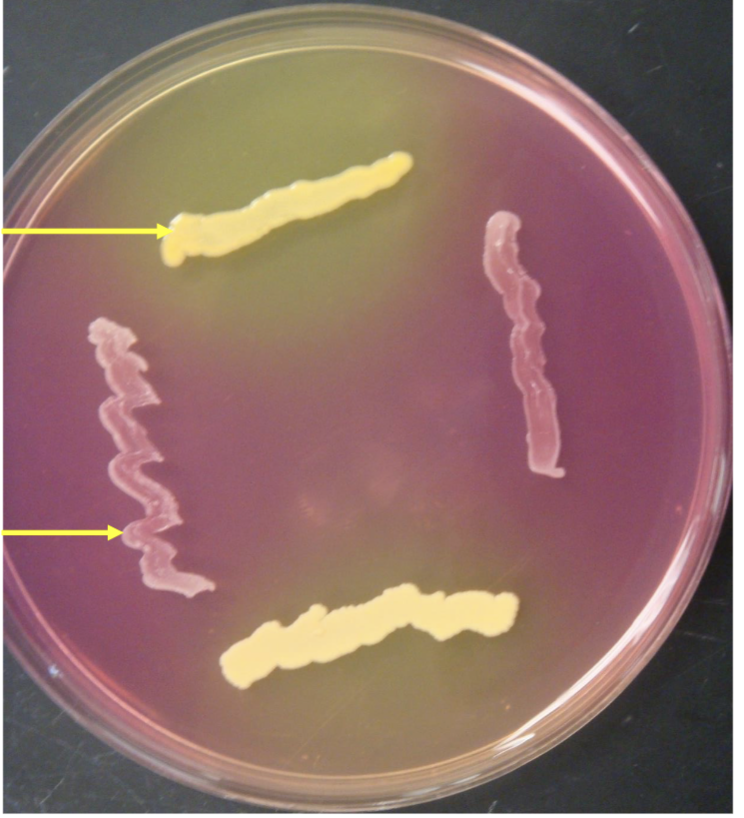
<p>what is this?</p>
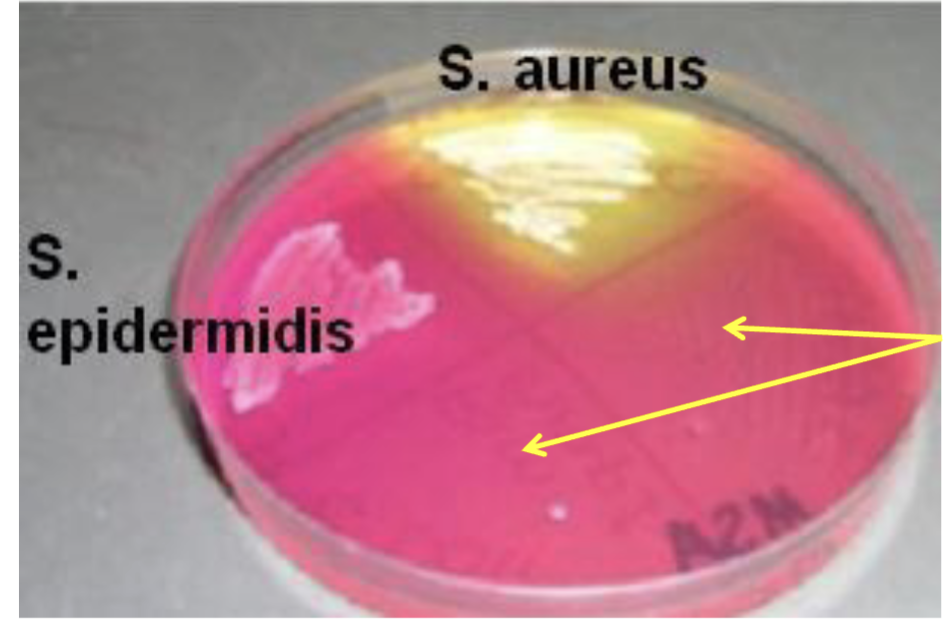
<p>what is this?</p>
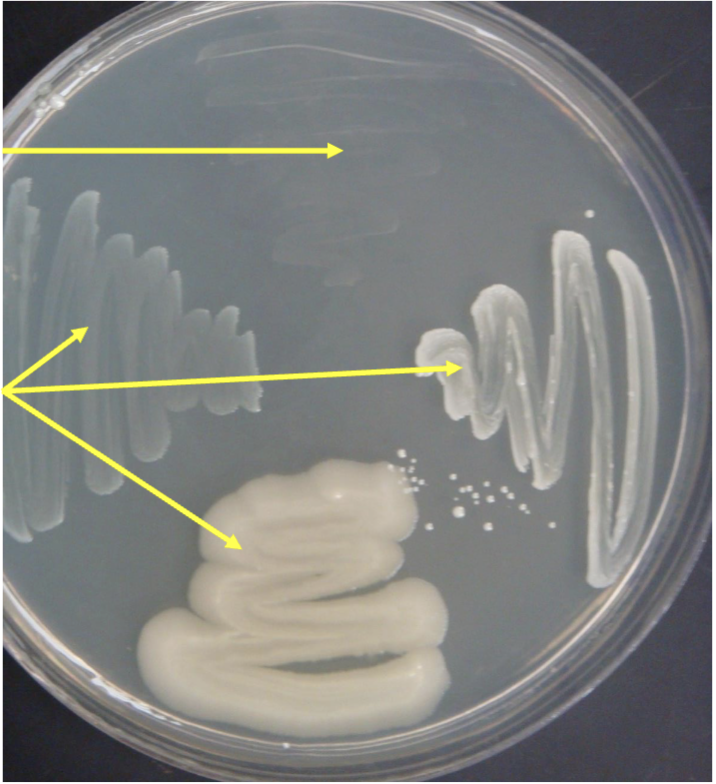
<p>bottom lines is what?</p>
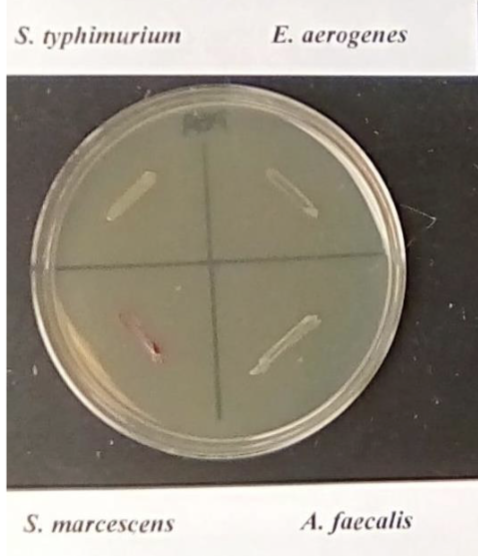
<p><span>Gram negative bacteria on PEA</span></p>
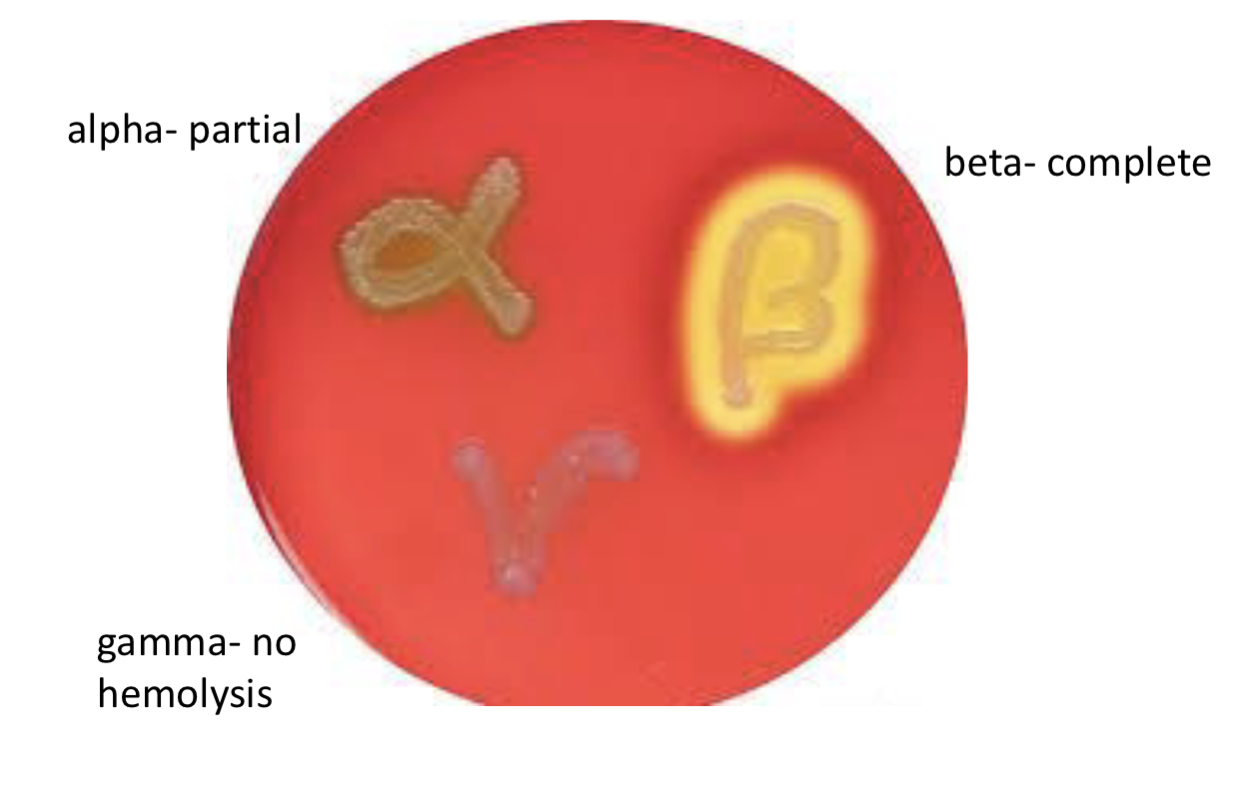
<p>what is this?</p>
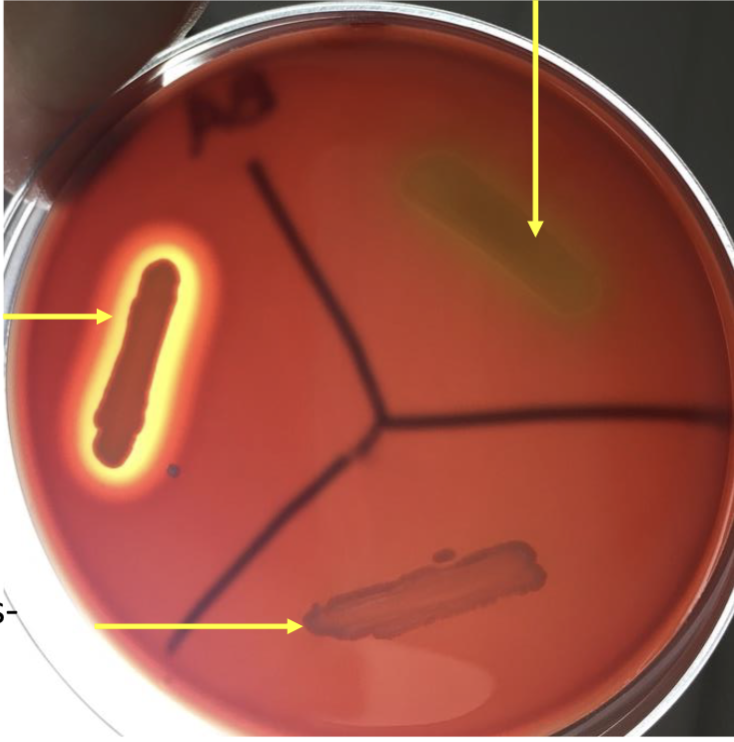
<p>what is this?</p>
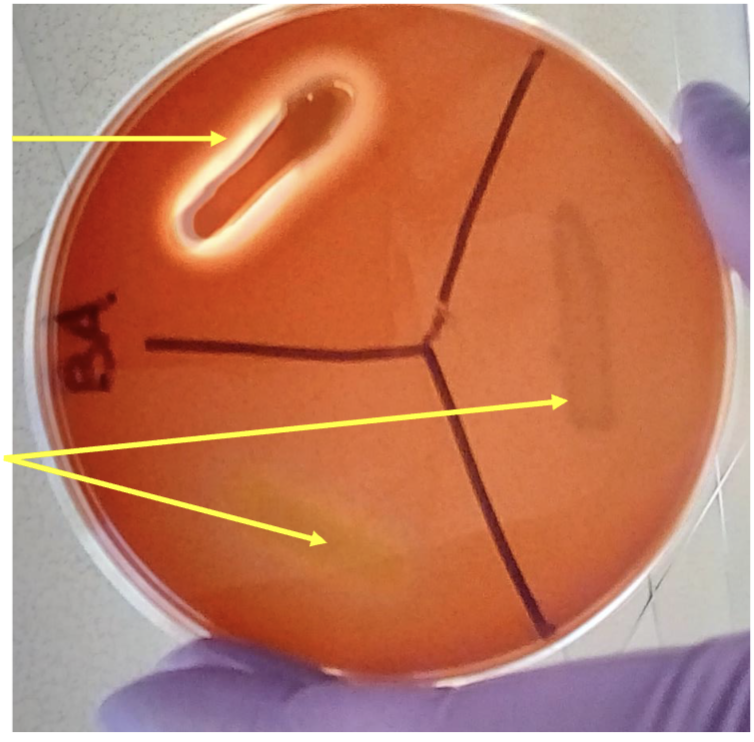
<p>what is bottom two lines?</p>
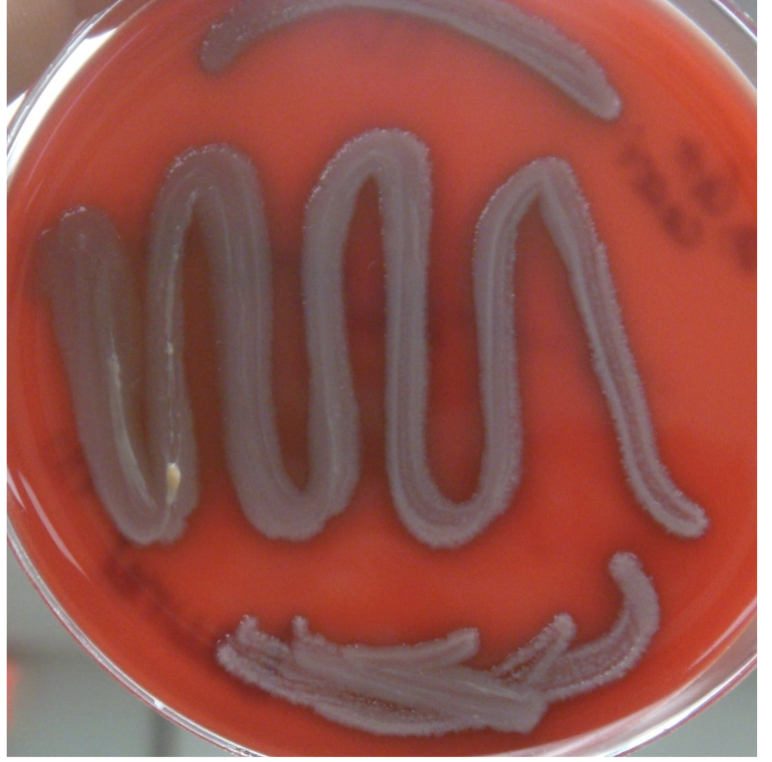
<p><span>blood agar- gamma hemolysis; no hemolysis</span></p>
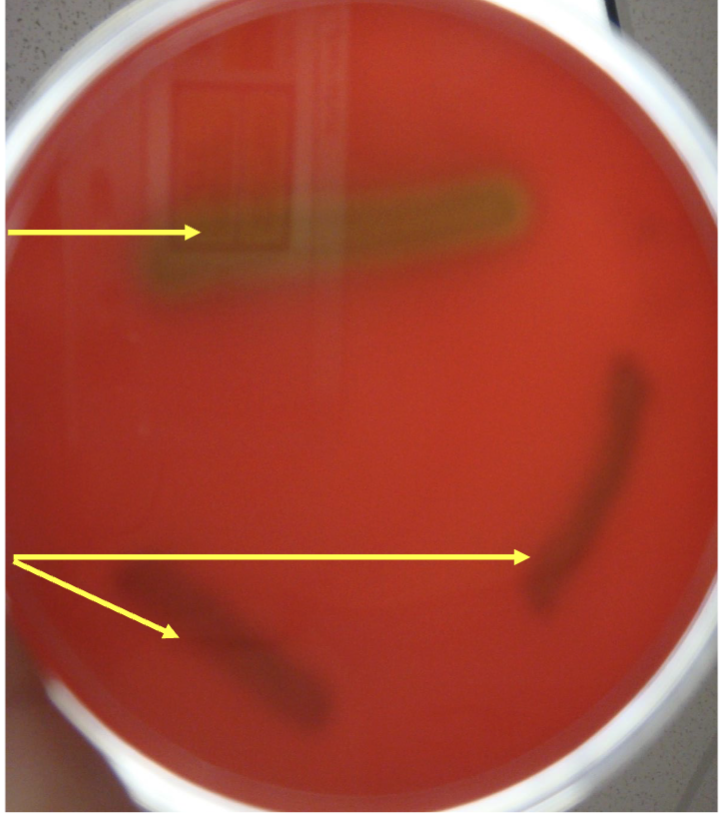
<p>bottom arrows?</p>

1/33
Looks like no tags are added yet.
Name | Mastery | Learn | Test | Matching | Spaced | Call with Kai |
|---|
No analytics yet
Send a link to your students to track their progress
what is this?
mannitol salt agar- MSA

top arrow bacteria?
Staphylococcus
aureus
salt tolerant,
-
yellow- ferments
mannitol

bottom line bacteria?
Staphylococcus
epidermidis
salt tolerant,
-
not yellow- does
not ferment
mannitol
what is this?
mannitol salt agar- MSA

what are the yellow lines?
Streptococcus
not salt tolerant-
no growth

whats this?
phenylethyl alcohol agar- PEA

top yellow mline?
Gram negative-
does not grow
on PEA
bottom lines is what?
Gram positives-
grow on PEA
Gram negative bacteria on PEA
microbiostatic on Gram negative bacteria
inhibits growth, reduces growth- does not kill
what is this?
blood agar- differential agar
shows hemolysis patterns

what’s this?
blood agar- BA

what is the left top line with yellow around?
beta hemolysis-
complete hemolysis
• Staphylococcus
aureus
• Streptococcus
pyogenes
• Streptococcus
agalactiae

what is bottom line?
Gamma hemolysis-
no hemolysis
what is this?
alpha hemolysis-
partial hemolysis

what is this?
blood agar- BA

what is top yellow line with yellow around?
beta hemolysis-
complete hemolysis
• Staphylococcus
aureus
• Streptococcus
pyogenes
• Streptococcus
agalactiae
what is bottom two lines?
gamma hemolysis-
no hemolysis

whats this?
blood agar- gamma hemolysis; no hemolysis
blood agar- gamma hemolysis; no hemolysis
Staphylococcus
epidermidis
-
Staphylococcus
saprophyticus
-
Enterococcus
faecalis
-
Streptococcus
bovis
-
Micrococcus
luteus

what is this?
blood agar- alpha hemolysis; partial hemolysis

what is top arrow?
alpha hemolysis-
partial hemolysis
Streptococcus
pneumoniae
-
Streptococcus
sanguinis
bottom arrows?
gamma hemolysis-
no hemolysis

what’s this?
Staphytect reaction

what’s top circle?
Staphylococcus aureus-
clumping positive

what’s bottom circle?
Staphylococcus epidermidis-
no clumping negative

what does the clumping mean on top circle?
Clumping and blue particulate after 20 seconds
positive for Staphylococcus aureus
antibodies bind compatible antigens

what does No clumping mean on bottom circle?
No clumping or blue particulate after 20 seconds
negative for Staphylococcus aureus
antibodies do not bind antigens; not compatible
different antigens on Staphylococcus epidermidis

what catalase does?
catalase reaction
breaks down hydrogen peroxide
forms water and oxygen
prevents damage by free radicals from hydrogen peroxide
distinguishes Staphylococcus from Streptococcus and Enterococcus

whats this?
Catalase reaction- results

what’s the left side white?
Staphylococcus- bubbles;
positive for catalase

what’s the right side?
Streptococcus- no bubbles;
negative for catalase

what’s this?
Catalase reaction- results

what bacteria is negative?
Streptococcus and Enterococcus
catalase negative

what bacteria would be positive?
Staphylococcus - bubbles
bubbles positive for catalase
releases O2